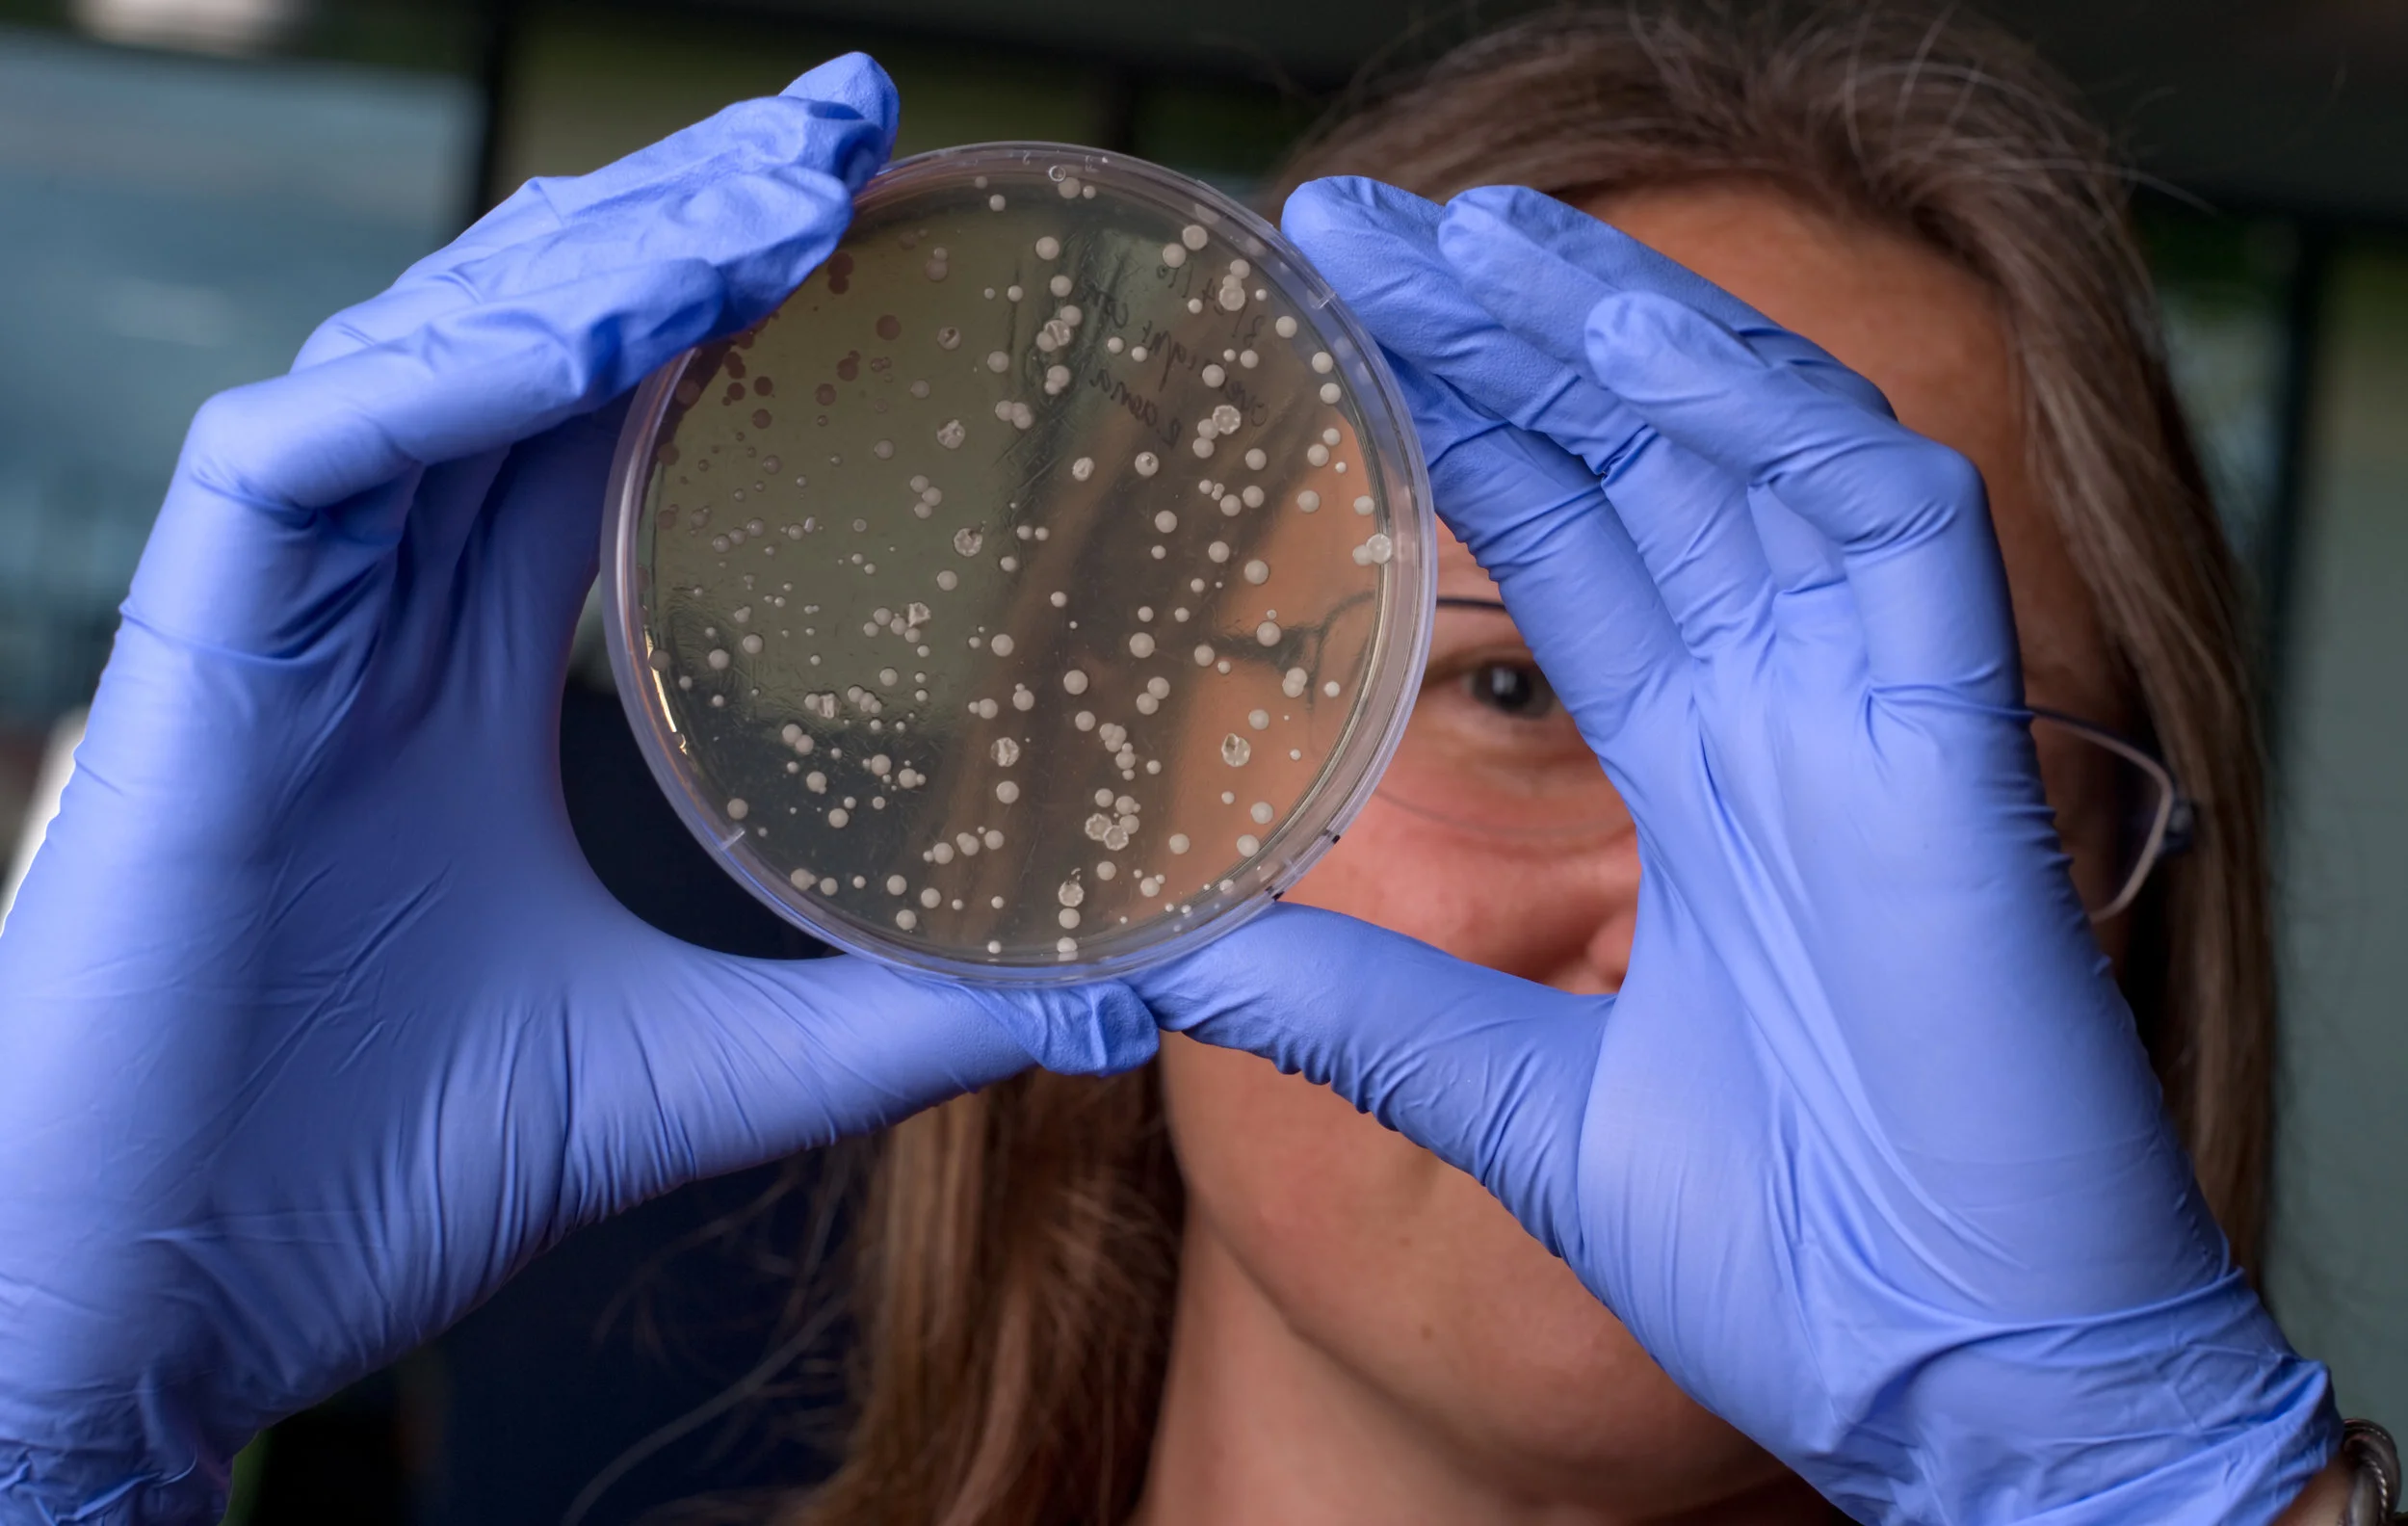
whiteson_160524_02_sz.jpg

Startup Guide for Inventors
If you are here, you are curious about commercializing an invention. The process can be complex. This guide can help.
Built through collaborative efforts it provides direction, suggestions, and various resources available to faculty inventors seeking to bring an invention to market. While it covers many paths, we encourage you to engage with UCI Beall Applied Innovation as soon as possible.